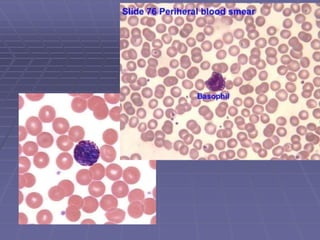
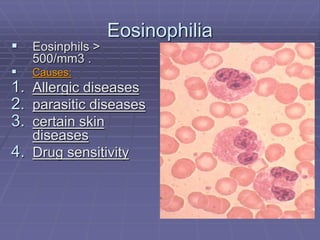
Eosinophilia
 Eosinphils >
500/mm3 .
 Causes:
1. Allergic diseases
2. parasitic diseases
3. certain skin
diseases
4. Drug sensitivity

White blood cells, also known as leukocytes, come in various types classified by their granule presence and cytoplasm staining. The five main types are granulocytes (neutrophils, eosinophils, basophils) and agranulocytes (lymphocytes, monocytes). Leukocytes are formed in bone marrow and live around 13-20 days, playing important roles in immunity and fighting infection and disease. Leukocyte disorders include increased or decreased cell counts caused by various infections, cancers, drugs, or medical conditions.